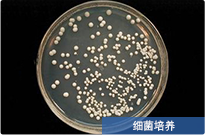

微生物實驗平臺
實驗中心由中國獸醫病理學家、985及211高校病理學博士生導師及優秀碩士相關專業人員組成,均獲得生物安全崗位培訓合格證書,并以此成立生物安全管理委員會,下設實驗室生物安全管理部門,配備專(兼)職管理人員,建立有標準的生物安全事件應急預案及實驗室事故應急處理措施,責任明確,任務到人。可為各大高等院校、生物醫藥企業、科研機構及醫院提供了病毒與微生物定制化一站式科研服務。
資深與研究對象
 微生物實驗室備案證書
微生物實驗室備案證書
服務項目


細菌培養
細菌分離純化
細菌染色
細菌拍照
菌種保存
菌株鑒定
菌株OD值檢測
菌株生長曲線
平板計數CFU測定
抑菌環測定
MIC/MBC測定
基因工程菌構建
單抗制備
代謝產物檢查/細菌生理生化檢測
檢測優勢





平臺掠影